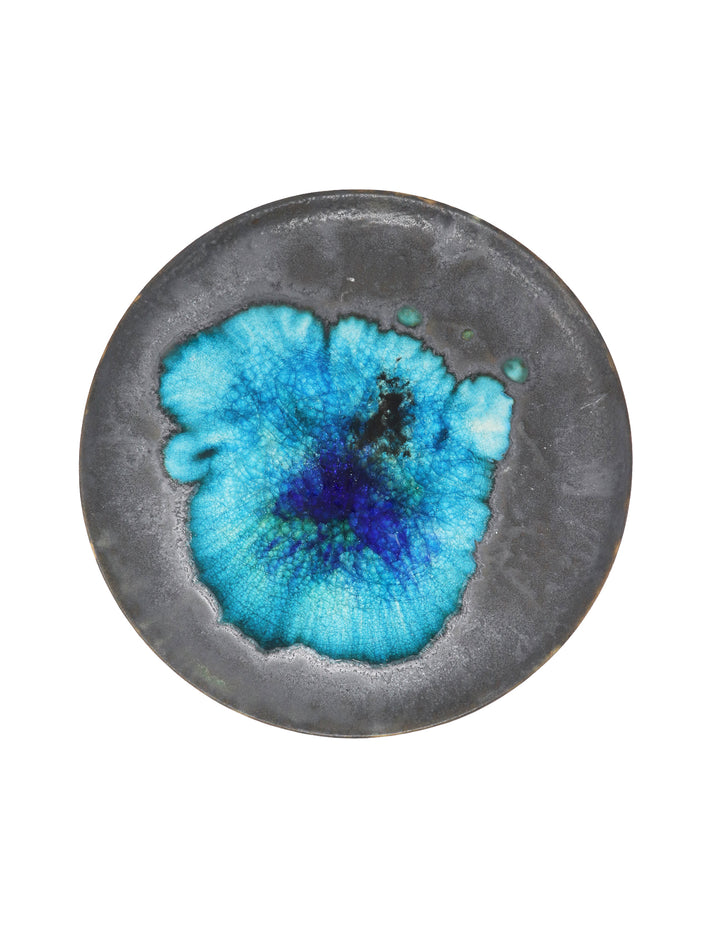

You may also like
-
Registries
-
Designers
Alden Adair Amanda Uprichard Anne Neilson Archies Baby Club Chic Bailey Boys Bala BALDIZ Barefoot Dreams Beaufort Bonnet Company Beekman Bella Tunno Bishop + Young Bobi Bourbon Barrel Brax Breda Bruce Julian BTB Los Angeles BuDhaGirl BUTRICH Carmen Sol Celia B Chubbies Christopher Radko Commando Cork Pops Cruz & RegisDAZE Demdaco Dock 6 Pottery Dolce Vita Emily McCarthy Enewton Etu Home Faceplant Dreams Fair Harbor Favorite Daughter Feetures Free Fly Freida Rothman French Connection Garland Bags Gemelli Godinger Gola Goosies Groove Life G3 Hampton Road Hampton Sun Haute Diggity Dog Ice Mule I-Sea Sunglasses Jack Black Jane IredaleKarina Grimaldi Kendra Scott Kissy Kissy KREWE Lafco New York Lanhtrophy Laura Park Lauren Dunn LBLOX Line and Dot Linnea Lollia Love Shack Fancy Love and Bikinis Love the Label Louvini Luli Fama Magnetic Me Melin Meri Meri Michael Wainwright Mignon Faget Mignonne Gavigan Miranda Frye Mizzen + Maine Nest OluKai Oncept Paige Pampa Bay PJ Harlow Posh Peanut Progeny Properly Tied PurseN Pistola PQ SwimQ Squared Queen of Sparkles Robeez Saint Satterfield Pottery Saxx Saylor Scout SedaFrance Sheila Fajl Show Me Your Mumu Simitri Skeem Design Sorrelli Sophistiplate Spanx Splits59 Spongellé Sun Bum sundays Susana Monaco The Foggy Dog The Good Patch Tipsy Threads Travis Matthew Tyler Candles Virtue Vinglace Vuori Warmies Wolf & Willa Zodax Roostas -
Women
-
-
Jewelry & Accessories
-
Kids
-
-
Home
-
-
-
Your cart is currently empty.
-
-
- Alden Adair
- Amanda Uprichard
- Anne Neilson
- Archies
- Baby Club Chic
- Bailey Boys
- Bala
- BALDIZ
- Barefoot Dreams
- Beaufort Bonnet Company
- Beekman
- Bella Tunno
- Bishop + Young
- Bobi
- Bourbon Barrel
- Brax
- Breda
- Bruce Julian
- BTB Los Angeles
- BuDhaGirl
- BUTRICH
- Carmen Sol
- Celia B
- Chubbies
- Christopher Radko
- Commando
- Cork Pops
- Cruz & Regis
-
- DAZE
- Demdaco
- Dock 6 Pottery
- Dolce Vita
- Emily McCarthy
- Enewton
- Etu Home
- Faceplant Dreams
- Fair Harbor
- Favorite Daughter
- Feetures
- Free Fly
- Freida Rothman
- French Connection
- Garland Bags
- Gemelli
- Godinger
- Gola
- Goosies
- Groove Life
- G3
- Hampton Road
- Hampton Sun
- Haute Diggity Dog
- Ice Mule
- I-Sea Sunglasses
- Jack Black
- Jane Iredale
-
- Karina Grimaldi
- Kendra Scott
- Kissy Kissy
- KREWE
- Lafco New York
- Lanhtrophy
- Laura Park
- Lauren Dunn
- LBLOX
- Line and Dot
- Linnea
- Lollia
- Love Shack Fancy
- Love and Bikinis
- Love the Label
- Louvini
- Luli Fama
- Magnetic Me
- Melin
- Meri Meri
- Michael Wainwright
- Mignon Faget
- Mignonne Gavigan
- Miranda Frye
- Mizzen + Maine
- Nest
- OluKai
- Oncept
- Paige
- Pampa Bay
- PJ Harlow
- Posh Peanut
- Progeny
- Properly Tied
- PurseN
- Pistola
- PQ Swim
-
- Q Squared
- Queen of Sparkles
- Robeez
- Saint
- Satterfield Pottery
- Saxx
- Saylor
- Scout
- SedaFrance
- Sheila Fajl
- Show Me Your Mumu
- Simitri
- Skeem Design
- Sorrelli
- Sophistiplate
- Spanx
- Splits59
- Spongellé
- Sun Bum
- sundays
- Susana Monaco
- The Foggy Dog
- The Good Patch
- Tipsy Threads
- Travis Matthew
- Tyler Candles
- Virtue
- Vinglace
- Vuori
- Warmies
- Wolf & Willa
- Zodax
- Roostas